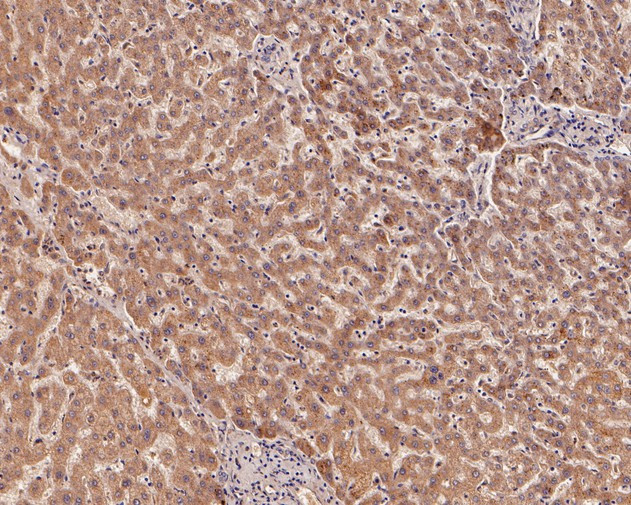
IGF1 (E peptide) Antibody in Immunohistochemistry (Paraffin) (IHC (P))

Search
Huabio
IGF1 (E peptide) Polyclonal Antibody
{{$productOrderCtrl.translations['antibody.pdp.commerceCard.promotion.promotions']}}
{{$productOrderCtrl.translations['antibody.pdp.commerceCard.promotion.viewpromo']}}
{{$productOrderCtrl.translations['antibody.pdp.commerceCard.promotion.promocode']}}: {{promo.promoCode}} {{promo.promoTitle}} {{promo.promoDescription}}. {{$productOrderCtrl.translations['antibody.pdp.commerceCard.promotion.learnmore']}}
图: 1 / 3
IGF1 (E peptide) Antibody (HA500107) in IHC (P)



产品信息
HA500107
种属反应
宿主/亚型
分类
类型
抗原
偶联物
形式
浓度
规格
纯化类型
保存液
内含物
保存条件
运输条件
靶标信息
IGF1 (Insulin-like growth factor-1) is structurally and functionally related to insulin but has a much higher growth-promoting activity. A variety of cellular responses are induced by IGF1, including cell proliferation, differentiation, migration, and survival. Further, IGF1 is a polypeptide growth factor that stimulates the proliferation of a wide range of cell types in muscle, bone, and cartilage tissue. IGF1 stimulates glucose transport in rat bone-derived osteoblastic (PyMS) cells and is effective at much lower concentrations than insulin, not only regarding glycogen and DNA synthesis but also with regards to enhancing glucose uptake. In circulation, IGFs are predominantly bound to binding proteins (IGFBPs) which prolong the half-life of the IGFs and play a role in delivering them to target tissues. IGF-I is known as one of the most potent activators of the AKT signaling pathway which is known to be a stimulator of proliferation and an inhibitor of programmed cell death. Moreover, mature human IGF-I is 100% homologous with bovine and porcine proteins. Low levels of IGF1 have been linked to Alzheimer's disease. IGF1 is processed from a precursor, bound by a specific receptor, and secreted. Defects in the IGF1 gene are a cause of insulin-like growth factor 1 deficiency and several transcript variants encoding different isoforms have been found.
仅用于科研。不用于诊断过程。未经明确授权不得转售。
篇参考文献 (0)
生物信息学
蛋白别名: H-IGF-1; IGF; IGF-I; IGF-IA; IGF-IB; IGF1; IGF1A; IGFIa; Insulin like growth factor; Insulin-like growth factor 1; insulin-like growth factor 1 (somatomedin C); Insulin-like growth factor I; insulin-like growth factor I precursor; insulin-like growth factor IB; insulin-like growth factor IB prepropeptide; insulin-like growth factor precursor; M-IGF-1; Mechano growth factor; MGF; OTTHUMP00000195084; R-IGF-1; Somatomedin C; Somatomedin-C; unnamed protein product
基因别名: IBP1; IGF; IGF-1; IGF-I; IGF1; IGFI; MGF
UniProt ID: (Human) P05019
Entrez Gene ID: (Human) 3479